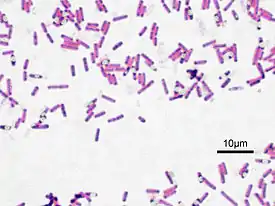

Бациллы (род)
Бациллы (лат. Bacillus) — обширный (около 217 видов[1]) род грамположительных палочковидных бактерий, образующих внутриклеточные споры. Большинство бацилл — почвенные редуценты. Некоторые бациллы вызывают болезни животных и человека, например сибирскую язву, токсикоинфекции (Bacillus cereus). Типовой вид — сенная палочка (Bacillus subtilis)typus[1].
| Бациллы | ||||||||||
|---|---|---|---|---|---|---|---|---|---|---|
Сенная палочка, окраска по методу Грама | ||||||||||
| Научная классификация | ||||||||||
| Международное научное название | ||||||||||
| Bacillus Cohn 1872 | ||||||||||
| ||||||||||
Систематика
До 1991 года в род Bacillus входило большое количество весьма несхожих видов, как на генотипическом уровне (процент ГЦ пар колебался от вида к виду в пределах от 32 % до 69 %), так и на уровне фенотипа. Сравнения нуклеотидных последовательностей 16S рРНК 51 вида[2] выявило по крайней мере 5 филогенетических групп. В 1992 году из рода Bacillus выделили 3 ацидофильных и термофильных вида в отдельный род Alicyclobacillus. В 1994 году выделили род Paenibacillus (куда вошёл известный продуцент антибиотика полимиксина — Paenibacillus polymyxa), в 1996 году выделили три рода — Aneurinibacillus, Brevibacillus и Halobacillus, в 1998 году — Virgibacillus, в 2001 году — Filobacillus и Jeotgalibacillus. Систематика рода Bacillus таким образом претерпела большие изменения за прошедшее время в связи с разъяснением филогенетических отношений внутри порядка Bacillales.
Биологические свойства

Бациллы являются аэробами или факультативными анаэробами, большинство представителей хемоорганогетеротрофы и растёт на простых питательных средах. Некоторые виды способны к нитратредукции. Крупные и среднего размера прямые или слабо изогнутые палочки, способные к образованию устойчивых к неблагоприятным воздействиям эндоспор (экстремальным температурам, высушиванию, ионизирующим излучениям, химическим агентам), большинство видов подвижно и обладают жгутиками расположенными перитрихиально, Bacillus anthracis образует капсулы. По методу Грама окрашиваются положительно. Недавние исследования[3] выявили, что бактерии вида Bacillus subtilis способны к каннибализму во время споруляции путём продукции токсинов в окружающую среду и дальнейшему лизису клеток своего вида.
Роль в биотехнологии
Bacillus subtilis является важнейшим продуцентом амилаз и протеиназ и используется в производстве, в том числе стиральных порошков. Bacillus thuringiensis, а также синтезируемые этим видом бактерий Cry-токсины используются в биозащите растений в качестве альтернативы синтетических инсектицидов. Также бациллы используются в генной инженерии в качестве хозяев для клонирования ДНК. Преимуществами бацилл как хозяев для клонирования ДНК является высокая изученность генома[4][5][6][7] многих видов, способность секретировать интактные белки в окружающую среду, нетребовательность большинства видов к питательной среде, высокая технологичность, а также возможность длительного хранения промышленных штаммов в виде высушенных спор. Поэтому для бацилл разработан ряд векторов, о информации и синтезе необходимого продукта (например pTL12[8], pHIS1525[9], hGH[10]).
Бактерия Bacillus mucilaginosus участвуют в разрушении силикатов и апатитов, за что были названы силикатными бактериями[11].
Клиническая значимость
Bacillus anthracis является возбудителем сибирской язвы и отнесена к II группе патогенности, Bacillus cereus является возбудителем пищевых токсикоинфекций у человека[12].
Примечания
- Genus Bacillus Архивировано 14 декабря 2008 года.
- Ash C., Farrow J.A.E., Wallbanks S., Collins M.D. [Phylogenetic heterogeneity of the genus Bacillus revealed by comparative analysis of small-subunit-ribosomal RNA sequences ] (англ.) // Lett. Appl. Microbiol.. — 1991. — No. 13. — P. 202—206.
- Cannibalism by Sporulating Bacteria — González-Pastor et al. 301 (5632): 510 — Science Signaling
- KEGG GENOME: Bacillus subtilis
- BSORF Top Page
- Genome Biology | Full text | Complete genome sequence of the industrial bacterium Bacillus licheniformisand comparisons with closely related Bacillusspecies
- Bacillus anthracis Ames Genome Page (недоступная ссылка)
- Bacillus plasmid vector pTL12 — incomplete (недоступная ссылка). Дата обращения: 3 августа 2008. Архивировано 27 сентября 2006 года.
- A Bacillus megaterium Plasmid System for the Production, Export, and One-Step Purification of Affinity-Tagged Heterologous Levansucrase from Growth Medium — Malten et al. 72 ( …
- U.S. Patent 5 334 531
- Няникова Г. Г., Виноградов Е. Я. Bacillus mucilaginosus: перспективы использования. — СПб.: НИИХ СПбГУ, 2000. — С. 3. — 124 с. — ISBN 5-7997-0213-1.
- Bacillus cereus
Ссылки
- Bacillus
- BACILLUS
- Gram-positive, Aerobic or Facultative Endospore-forming Bacteria (formerly, «The Genus Bacillus»)
Научные ссылки
- Ссылки на PubMed для Bacillus
- Ссылки на PubMed Central для Bacillus
- Ссылки на Google Scholar для Bacillus